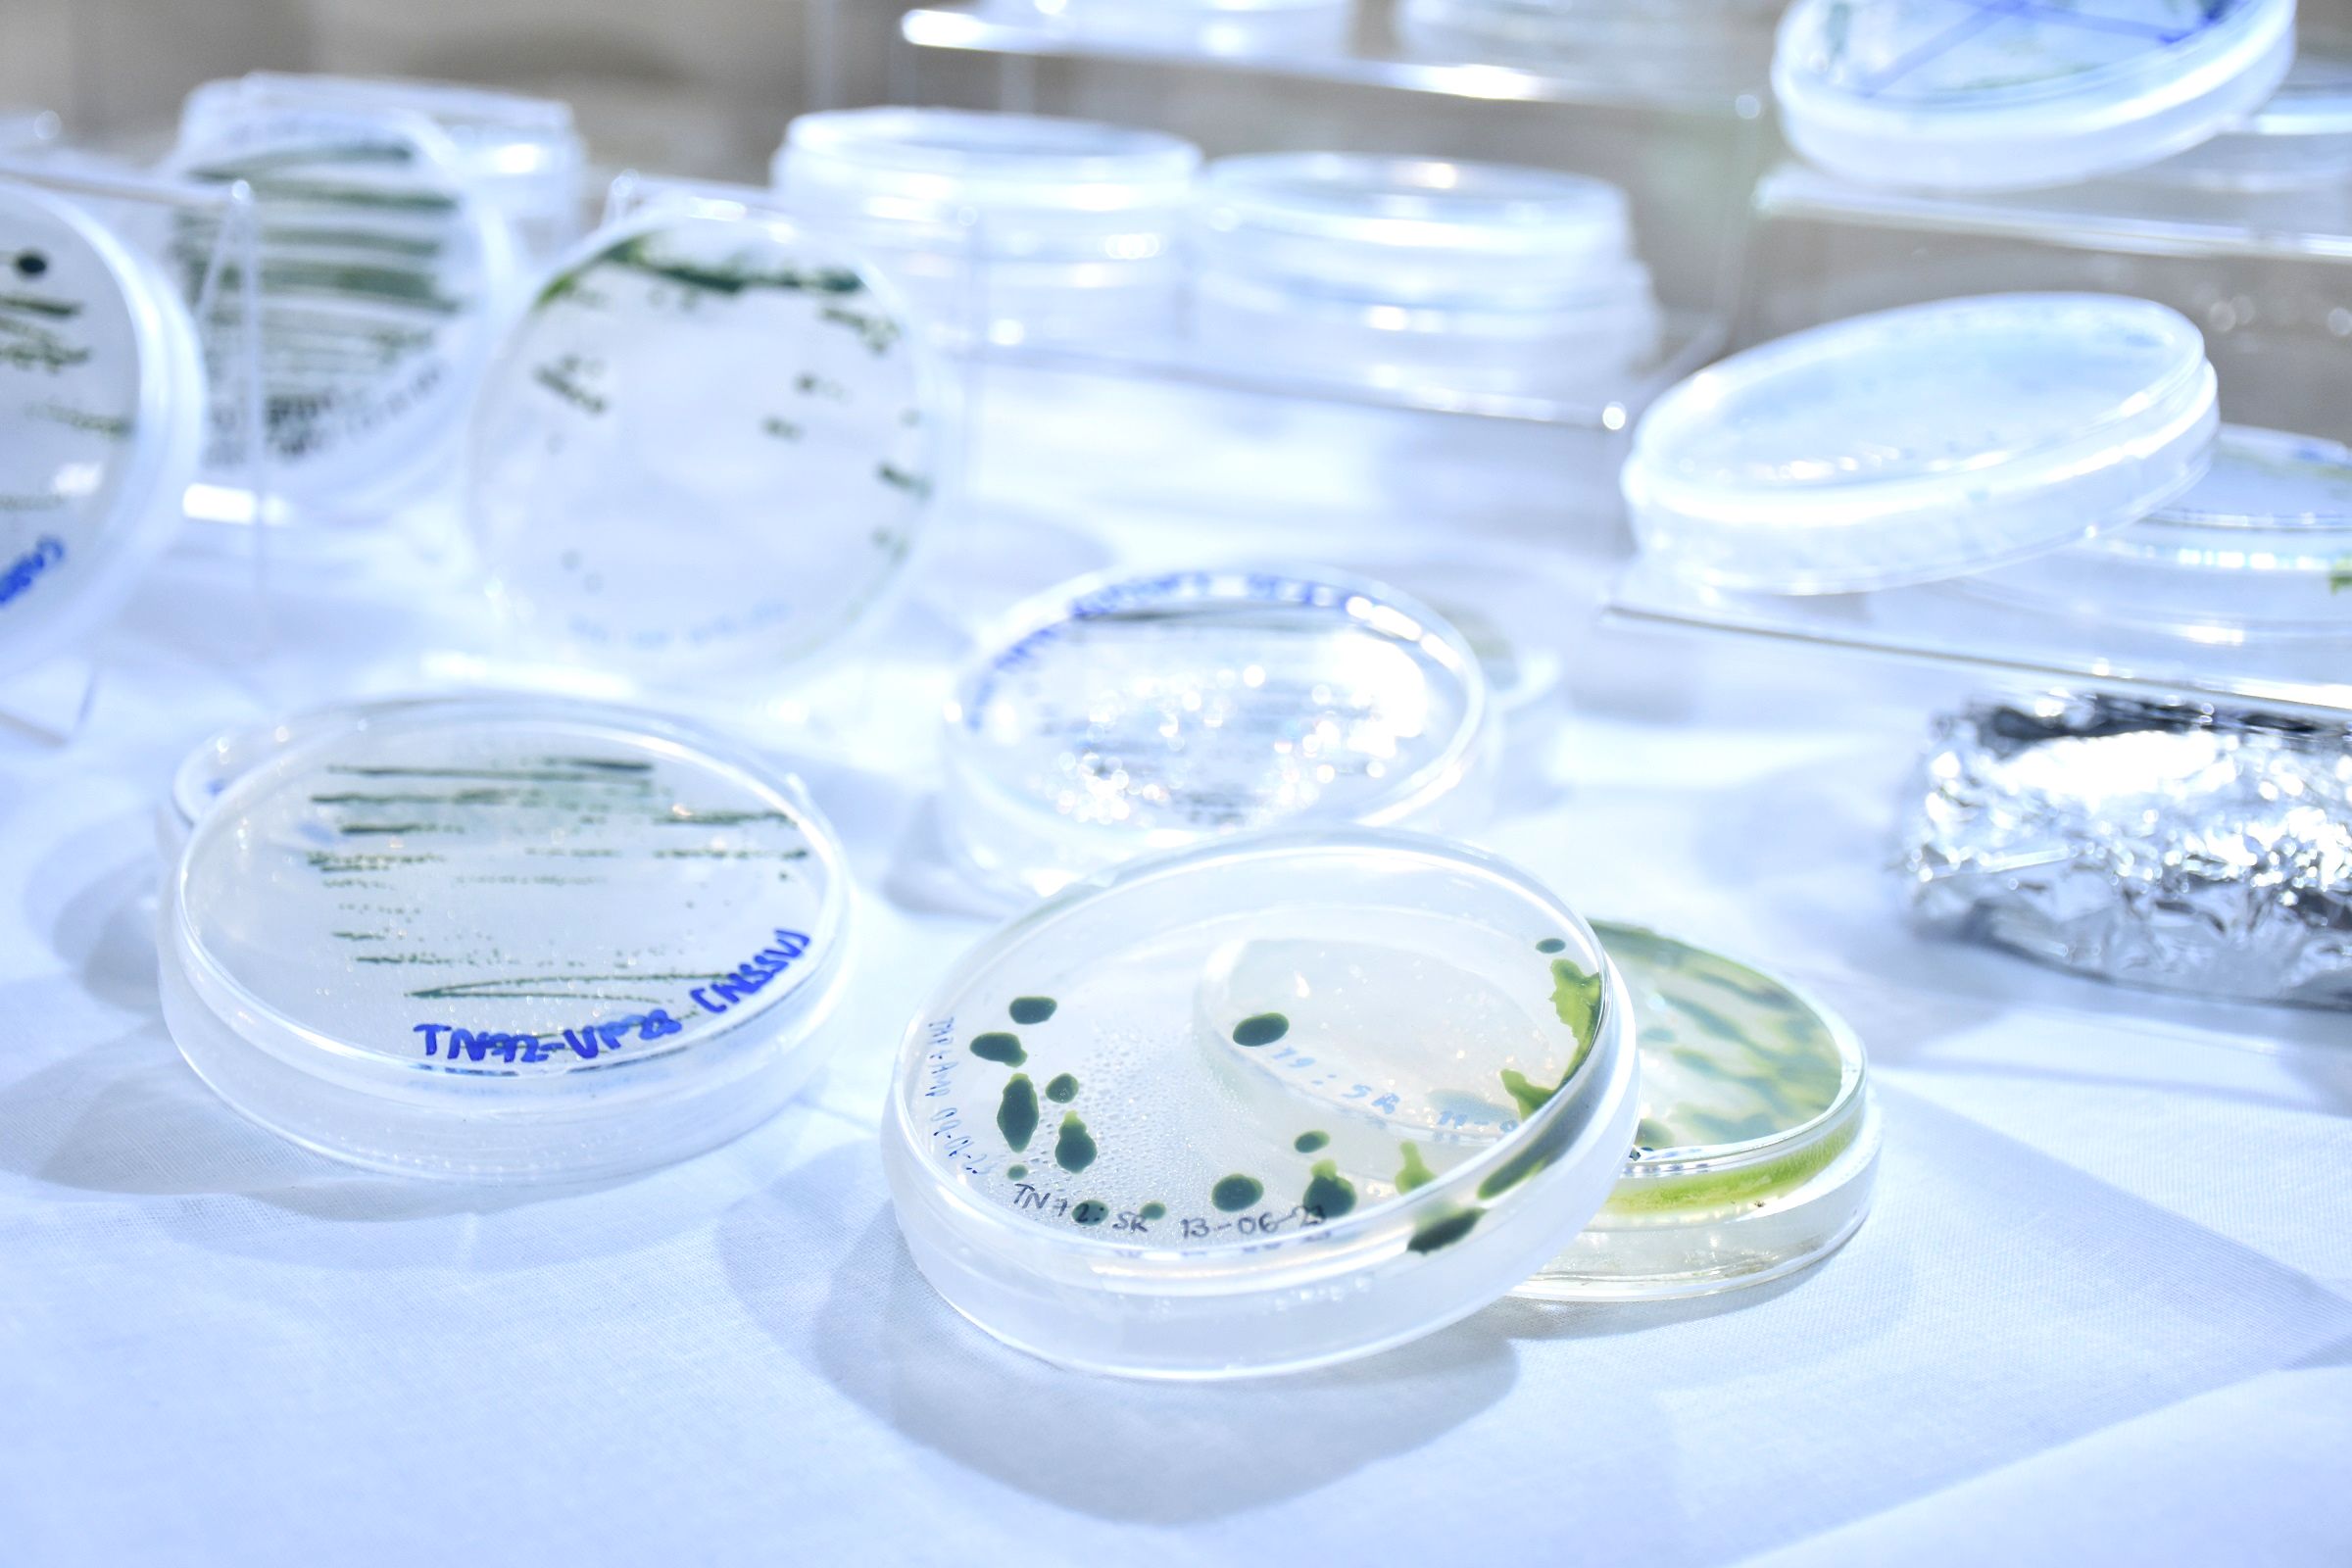
07 เทคโนโลยีชีวภาพของสาหร่ายเซลล์เดียว 1

ไบโอเทค สวทช. มุ่งมั่นวิจัยเทคโนโลยีชีวภาพด้านสาหร่าย กว่า 20 ปี หนุนอุตฯ เพาะเลี้ยงสัตว์น้ำไทย หวังเป็นผู้นำส่งออกสัตว์น้ำโลกได้อีกครั้ง
 .
. 
 .
. 
ศูนย์พันธุวิศวกรรมและเทคโนโลยีชีวภาพแห่งชาติ (ไบโอเทค) สำนักงานพัฒนาวิทยาศาสตร์และเทคโนโลยีแห่งชาติ (สวทช.) ดำเนินงานวิจัยและพัฒนาเทคโนโลยีชีวภาพด้านสาหร่ายมาอย่างต่อเนื่องมากกว่า 20 ปี มีหน่วยวิจัยเฉพาะด้าน ได้แก่ ทีมวิจัยเทคโนโลยีชีวภาพปลาและกุ้ง ซึ่งร่วมกับคณะวิทยาศาสตร์ มหาวิทยาลัยมหิดล พัฒนาการนำส่งสาหร่ายเซลล์เดียวดัดแปลงทางการกินช่วยแก้ไขปัญหาโรคในกุ้งและสัตว์น้ำอื่น และทีมวิจัยชีวศาสตร์และชีววิทยาระบบ ซึ่งร่วมกับมหาวิทยาลัยเทคโนโลยีพระจอมเกล้าธนบุรี พัฒนาชีววิทยาระบบของสาหร่ายครบวงจร ตั้งแต่ต้นน้ำถึงปลายน้ำ เพื่อช่วยสนับสนุนอุตสาหกรรมการเพาะเลี้ยงสัตว์น้ำ (Aquaculture) ให้เกิดความยั่งยืน ลดการพึ่งพาเทคโนโลยีต่างประเทศ สร้างจุดแข็งการเพาะเลี้ยงสัตว์น้ำไทย หวังกลับมาเป็นผู้ส่งออกสัตว์น้ำแถวหน้าของโลกได้อีกครั้ง

ดร.วรรณวิมล ศักดิ์เสมอพรหม หัวหน้าทีมวิจัยเทคโนโลยีชีวภาพปลาและกุ้ง ไบโอเทค สวทช. เปิดเผยว่า ตลอดระยะเวลา 20 ปีที่ผ่านมา ม.มหิดล และไบโอเทค สวทช. ได้ร่วมกันสร้างองค์ความรู้ทางวิทยาศาสตร์ด้านเทคโนโลยีชีวภาพเพื่อนำไปสู่การแก้ปัญหาและส่งเสริมการเพาะเลี้ยงสัตว์น้ำอย่างต่อเนื่อง โดยเฉพาะการเพาะเลี้ยงกุ้งเศรษฐกิจ เกิดเป็น “หน่วยวิจัยเพื่อความเป็นเลิศเทคโนโลยีชีวภาพกุ้ง (Centex Shrimp)” เพื่อพัฒนางานวิจัยที่เกี่ยวกับเรื่องโรคกุ้งและโรคในสัตว์น้ำชนิดอื่น โดยงานวิจัยได้พัฒนาเทคโนโลยีชีวภาพของสาหร่ายเซลล์เดียวซึ่งทำให้การใช้จุลชีพดัดแปลงในอุตสาหกรรมเลี้ยงกุ้งมีความเป็นไปได้มากขึ้น
“การดำเนินงานวิจัยและพัฒนาของทีมวิจัยได้สร้างผลกระทบในหลายภาคส่วน ทั้งในด้านเศรษฐกิจที่มีการนำผลงานวิจัยและองค์ความรู้ไปใช้ในอุตสาหกรรมการเพาะเลี้ยง และมีเอกชนด้านอาหารและเวชภัณฑ์นำไปต่อยอดเชิงพาณิชย์เพื่อสร้างมูลค่าเพิ่ม ทั้งนี้ ทีมวิจัยหวังว่า วันหนึ่งในอนาคตอันใกล้นี้ เทคโนโลยีชีวภาพของสาหร่ายเซลล์เดียวจะเป็นกลไกหนึ่งที่มีส่วนช่วยเพิ่มประสิทธิภาพในการจัดการฟาร์ม ส่งผลให้คุณภาพชีวิตของเกษตรกรดีขึ้น ส่งผลให้ประเทศไทยกลับมาเป็นผู้นำการส่งออกสัตว์น้ำได้อีกครั้ง” ดร.วรรณวิมล กล่าว

ด้าน ดร.อภิรดี หงส์ทอง หัวหน้าทีมวิจัยชีวศาสตร์และชีววิทยาระบบ ไบโอเทค สวทช. กล่าวว่า ความร่วมมือระหว่าง ไบโอเทค สวทช. กับ ม.เทคโนโลยีพระจอมเกล้าธนบุรี เริ่มมาตั้งแต่ปี 2530 ด้วยโครงการ “การนำน้ำทิ้งจากโรงงานแป้งมันสำปะหลังมาเป็นแหล่งอาหารเพื่อใช้เลี้ยงสาหร่ายสไปรูลิน่า” เกิดเป็นการจัดตั้ง “กลุ่มวิจัยเทคโนโลยีชีวภาพสาหร่าย (Algal Biotechnology)” ที่ดำเนินงานโดยทีมอาจารย์นักวิจัย มจธ. และนักวิจัยไบโอเทค โดยงานวิจัยและพัฒนาของกลุ่มวิจัย เน้น 3 แนวทางหลัก ได้แก่ (1) การเพาะเลี้ยง (2) สารเคมีมูลค่าสูง และ (3) การศึกษาด้านชีวโมเลกุล มุ่งเน้นให้เกิดความรู้ความเข้าใจระดับชีวโมเลกุลของสาหร่ายสไปรูลิน่า รวมถึงกลไกการควบคุม และการสังเคราะห์สารออกฤทธิ์ชีวภาพ (Bioactive compound)
 .
.
.
. 
“กลุ่มวิจัยเทคโนโลยีชีวภาพสาหร่าย มีองค์ความรู้ (knowledge) และความชำนาญ (know-how) ในเรื่องชีววิทยาระบบ (system biology) เป็นอย่างดี งานวิจัยครบวงจร ทั้งนี้ เพื่อผลักดันให้เกิดเป็นเครือข่ายระหว่างกัน แลกเปลี่ยนข้อมูลทางวิชาการ อันจะนำไปสู่การให้คำปรึกษาและแก้ไขปัญหาเพื่อเพิ่มประสิทธิภาพการผลิตของภาคอุตสาหกรรม และผลิตงานวิจัยได้ตรงความต้องการของภาคอุตสาหกรรม ตลอดจนพัฒนาสู่ความเป็นเลิศทางเทคโนโลยีชีวภาพสาหร่ายของกลุ่มวิจัยต่อไป” ดร.อภิรดี กล่าว
เผยแพร่ข่าว : นางสาวพรชิตา รุกขชาติ
กลุ่มสื่อสารองค์กร กองกลาง
กระทรวงการอุดมศึกษา วิทยาศาสตร์ วิจัยและนวัตกรรม
โทรศัพท์ 0 2333 3700 ต่อ 3972 โทรสาร 0 2333 3834
e-mail : pr@mhesi.go.th
Facebook : @MHESIThailand
Twiiter : @MHESIThailand
Call Center โทร.1313
![]()
- อว.พารับส่วนลด
- User Menu (Discount)
- แนะนำหน่วยงาน
- ภาพข่าวและกิจกรรม
กระทรวงการอุดมศึกษา วิทยาศาสตร์ วิจัยและนวัตกรรม (อว.)
เป็นหน่วยงานของรัฐที่จัดตั้งขึ้นเพื่อขับเคลื่อนการอุดมศึกษาไทย วิทยาศาสตร์ วิจัยและนวัตกรรม ไปสู่มาตรฐานในระดับสากล และเพิ่มอันดับความสามารถการแข่งขันในระดับนานาชาติอย่างยั่งยืน ไม่ได้มีวัตถุประสงค์เพื่อแสวงหากำไร หากท่านพบว่ามีข้อมูลใดๆ ที่ละเมิดทรัพย์สินทางปัญญาปรากฏอยู่ในเว็บไซต์นี้ โปรดแจ้งให้ทราบ เพื่อดำเนินการแก้ปัญหาดังกล่าวโดยเร็วที่สุดต่อไป
© 2020 Ministry of Higher Education, Science, Research and Innovation. ALL RIGHTS RESERVED.




